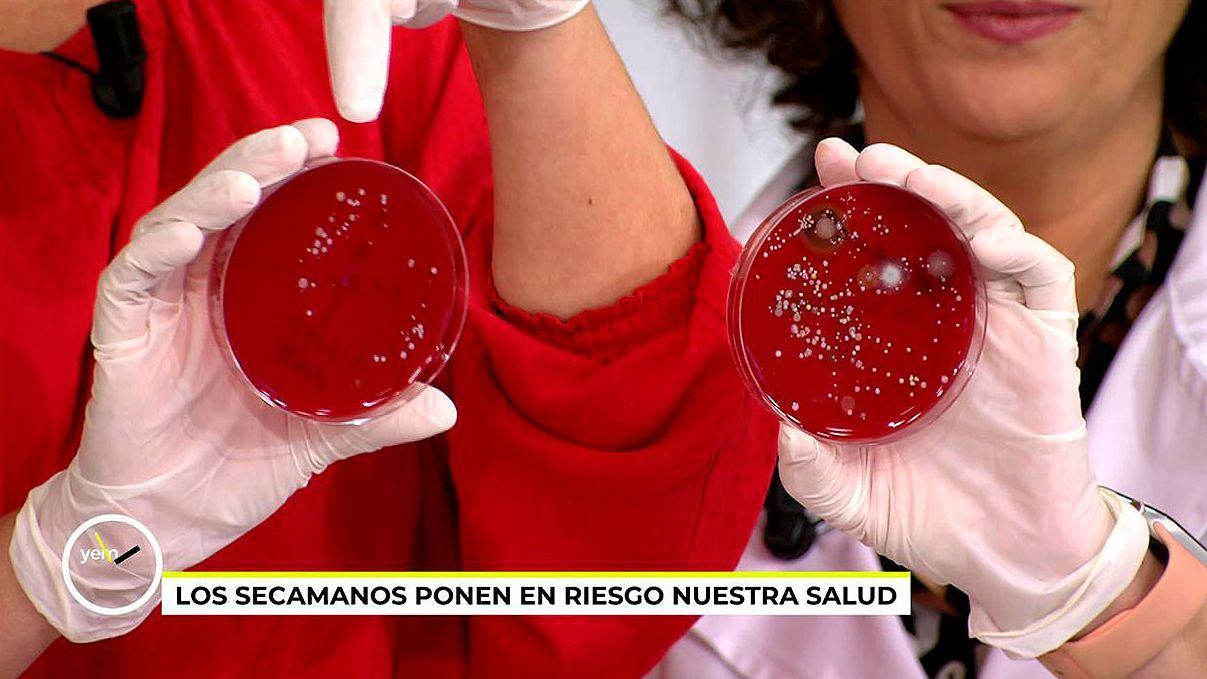
Las muestras tomadas de las manos de Verónica Dulanto

Utilizar el secamanos puede dejar bacterias y hongos en tus manos: los motivos y cómo evitarlo

Todo depende de la limpieza del lugar en el que esté colocado dado que el secamanos expulsa aire recogido del lugar
Verónica Dulanto toma muestras de cuatro baños públicos
La farmacéutica Marisa García Alonso nos explica qué ha hallado en las muestras: bacterias y hongos
Imagínese que va a un baño público, se lava las manos y luego utiliza el secamanos ¿Cree que están verdaderamente limpias? Verónica Dulanto lleva a cabo una investigación en ‘Ya es mediodía’ cuya conclusión es muy clara…
La periodista ha tomado cuatro muestras en cuatro baños públicos: en una cafetería, en un restaurante, en los baños del transporte público y en los de una universidad. Además, en una de ellas ha hecho la prueba de secarse una mano al aire y otra bajo el secamanos y los resultados no pueden ser más claros.
Hongos y bacterias en los resultados
Tras analizarlos durante 24 horas en un laboratorio, Marisa García Alonso, farmacéutica, nos daba los resultados en ‘Ya es mediodía’. La presentadora le preguntaba si era mejor que se pusiera los guantes y Marisa se lo aconsejaba: “Mejor para ti, sí”.
“El peor es la universidad, con diferencia”, nos transmitía la farmacéutica y, enseñándonos la muestra, destacaba que había muchas bacterias y algún hongo. Lo mismo sucede con las muestras tomadas de las manos de Verónica, la que se secó al aire apenas tiene nada, pero la que se secó bajo la máquina estaba lena de ellos.
Pero ¿Por qué sucede esto? La explicación es sencilla, la máquina coge aire del ambiente, lo calienta y lo expulsa, con lo que si el ambiente no está limpio, el aire que expulse la máquina tampoco.
¿La mejor muestra de todas? Las de la cafetería.